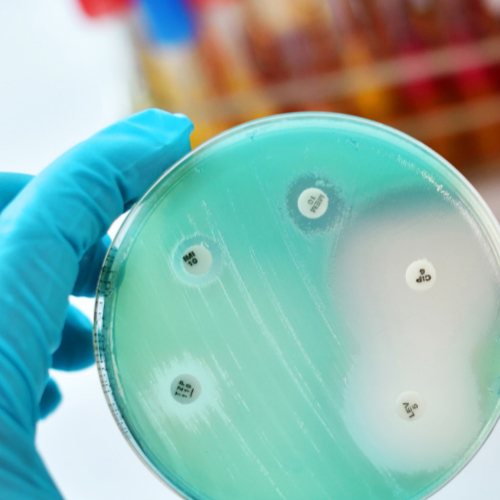
AMR-Explainer.jpg

Policy briefings
The Microbiology Society issues topical briefing papers, which provide need-to-know information on various subjects such as hospital-acquired infections, climate change and pandemic influenza. These resources are prepared with the help of our members. To request hard copies of these resources please contact our Policy Officer on [email protected].
- Order by:
- Date
- A-Z
-
A Sustainable Future: Antimicrobial Resistance Policy Report
December 2020
AMR is a slow-moving pandemic, which already causes at least 70,000 deaths a year globally. Unchecked, the impact of AMR will continue to grow and has the potential to become the greatest future threat to human health and well-being.
-
A Sustainable Future: Circular Economy Policy Report
December 2020
Exploitation of material resources and increased pressure on natural ecosystems have raised concerns over potential future resource risk and supply failures worldwide. In recent years, interest in a circular model that looks beyond the current linear ‘take-make-dispose’ industrial model has surged among scientists, policy makers and business actors. The circular economy is based on the principles of designing out waste and pollution, keeping products and materials in use, and regenerating natural systems.
-
A Sustainable Future: Project Statement
December 2020
The United Nations 17 Sustainable Development Goals (SDGs), including “good health and well-being”, “gender equality” and “affordable and clean energy”, build on the success of the Millennium Development Goals to cement hundreds of years of incremental human progress with the support of a strong international community. The global goals are a universal call to action to end poverty, protect the planet and ensure that all people enjoy peace and prosperity. Many of the steps that will be taken on the long road towards achieving the SDGs will involve outputs from microbiological research. The major policy decisions needed to set us on this journey require knowledge of relevant microbial activities and how these can be channelled for the greater benefit.
-
A Sustainable Future: Soil Health Policy Report
December 2020
Soils are critically important to the functioning and sustainability of the planet. They provide a range of essential functions, including producing the vast majority of our food, filtering our water and regulating climate. Most of these functions are underpinned by micro-organisms, making the knowledge of how they work of vital importance. In spite of this, soils are being degraded at an alarming rate. Twenty-four billion tons of fertile soil are annually lost from agricultural systems worldwide and it is estimated that 60-70% of EU soils are unhealthy.
-
Antimicrobial Resistance
June 2017
Increasing levels of antimicrobial resistance mean that conditions such as tuberculosis, HIV and malaria are again becoming increasingly difficult to treat. Antimicrobial-resistant infections cause over 700,000 deaths worldwide annually, and this number is set to grow. There is a need to address the overuse of antimicrobials in medicine and agriculture, and for research to develop new antimicrobials and alternative antimicrobial therapies.
-
Antimicrobial Resistance (AMR) in Wastewater
March 2025
AMR occurs when disease-causing bacteria, viruses, fungi and parasites (pathogens) are no longer affected by the medicines that have been developed to target them. Drug-resistant pathogens can cause infections that are difficult or impossible to treat; they increase the risk of disease spread and can lead to severe illness, disability and death.
-
Antimicrobial Resistance explainer
May 2020
In 2015 the United Nations (UN) adopted the Sustainable Development Goals (SDGs), a set of targets for the world to achieve by 2030. AMR is a very real threat to achieving the UN SDGs, particularly those associated with poverty, food production, the environment and sustainable economic growth. AMR is a naturally occurring process, whereby micro-organisms (bacteria, viruses, fungi and parasites) can change and adapt over time, either by modifying the target of the antimicrobial, or by developing and exchanging resistance genes.
-
Antimicrobial Resistance in the UK: Diagnostics and Surveillance
November 2023
The rise of antimicrobial resistance (AMR) is one of the most urgent global threats to public health in the 21st century. AMR refers to disease-causing microbes (also known as pathogens) evolving and gaining resistance to drugs and substances that were once effective treatments against infections (antimicrobials). It poses significant challenges to current clinical care, health economies, animal and plant health as well as the environment. Microbiologists from across the world are committed to developing innovative solutions to combat AMR and reduce its impact on global health.
-
Antimicrobial Resistance in the UK: Therapeutics and Vaccines
November 2023
The rise of antimicrobial resistance (AMR) is one of the most urgent global threats to public health in the 21st century. AMR refers to disease-causing microbes (known as a pathogens) evolving and gaining resistance to drugs and substances that were once effective treatments against infections (antimicrobials). It poses significant challenges to clinical care, health economies, animal and plant health as well as the environment. Microbiologists from across the world are committed to developing innovative solutions to combat AMR.
-
Ash dieback
November 2012
Ash dieback is an infectious disease of ash trees caused by a microscopic fungus, Chalara fraxinea.
-
Banana disease
April 2014
Fusarium wilt is caused by a fungus, Fusarium oxysporum f.sp. cubense. The TR4 strain targets Cavendish bananas, as well as many other banana varieties.
-
Biofilms explainer
February 2019
Biofilms are communities of micro-organisms that stick to each other and to surfaces. They form in aqueous environments when free-floating micro-organisms attach and adhere to surfaces in response to cues in the environment such as changes in pH and nutrient concentration. The biofilm matures as attached micro-organisms multiply, colonising the surface and recruiting new members which are embedded in self-secreted extracellular polymeric substance (EPS), a sticky slime-like material consisting of DNA, polysaccharides, and proteins, forming a structured 3D matrix.
-
Biofuels
August 2011
Biofuels are renewable liquid or gaseous fuels made by and/or from living organisms or the wastes that they produce. Microbes play a crucial role in the production of sustainable biofuels. The Society also responded to consultations on biofuels in 2010 and 2006.
-
Circular Economy explainer
May 2020
In an increasingly expanding global economy, within a resource-constrained environment; concerns over the exploitation and possible future scarcity of natural resources are rapidly rising. In recent years, interest in a circular model that looks beyond the current linear ‘takemake-waste’ industrial model, has surged among scientists, policy makers and business actors. The circular economy is based on the principles of designing out waste and pollution, keeping products and materials in use, and regenerating natural systems.
-
Climate change
May 2010
The role of microbes in climate change cannot be ignored. They play an important role as both users and producers of greenhouse gases. Both natural and human-induced fluxes of carbon dioxide, methane and nitrous oxide are dominated by microbiology.
-
Climate Change: Microbes as Our Allies
February 2022
The effects of climate change are already evident across the globe. Habitats are disappearing, sea levels are rising, and the polar ice caps are melting. The communities most affected are struggling to cope with a rapidly changing world. Microbes are directly associated with both the production and consumption of greenhouse gasses, making them an important component in climate change models. Microbiology research is instrumental for the monitoring and mitigation of climate change and has revealed ways in which we can harness the power of microbes to avoid climate catastrophe.
-
Clostridium difficile
November 2009
Clostridium difficile is a bacterium carried in the guts of a wide range of animals, as well as up to 3 % of humans. Clostridium difficile infection is the most important cause of hospital-acquired diarrhoea.
-
Couch potato or elite athlete?
July 2012
Watch Mike Gleeson's talk: Fighting Fit - how exercise affects your immunity and susceptibility to infection
-
Emerging zoonotic diseases
June 2015
Emerging zoonotic diseases are infectious diseases that can be transmitted between vertebrate animals and humans, which have been newly identified, or are increasing in incidence or geographic range. Examples include Ebola, avian influenza and West Nile virus. They pose threats to global public health and economic security.
-
Endemic livestock disease
July 2014
Endemic livestock diseases are found in cows, pigs, sheep and poultry and include mastitis, tuberculosis, avian colibacillosis, and salmonellosis. They are caused by infectious micro-organisms, some of which rapidly evolve to escape control.
-
Energy from food waste
January 2015
Food waste in the UK is a valuable, sustainable energy source, once anaerobic digestion has broken it down into biogas.
-
Food security from the soil microbiome
December 2015
The soil microbiome – the community of soil micro-organisms found in soil – is crucial for food security and the health of our soils. Microbiologists are investigating better understanding of the diversity and function of the soil microbiome, and harnessing it as a tool for sustainable agricultural intensification.
-
Food-borne pathogens
December 2011
Food-borne pathogens are a major threat to food safety. Most food-borne illness is caused by infection by microbial pathogens that have entered the food chain at some point from farm to fork. The World Health Organization (WHO) estimates that food-borne and water-borne diarrhoeal diseases together kill around 2.2 million people annually.
-
H1N1 (2009) 'swine flu'
June 2011
A novel H1N1 virus emerged from Mexico in April 2009 and spread so rapidly that the World Health Organization (WHO) declared a global flu pandemic on 11 June. H1N1 (2009) is now circulating as seasonal flu and has been incorporated into the 2010/2011 seasonal flu vaccine.
-
Hand hygiene
February 2009
Not all infections can be avoided, but one of the easiest methods of prevention is hand washing, in the home as well as in the hospital.
-
HIV
August 2010
HIV is an RNA retrovirus that infects specific white blood cells with the CD4 receptor on their surface (CD4+ cells). CD4 is hijacked by HIV which uses it to gain access to the cell.
-
Human Fungal Diseases
March 2016
Over a billion people suffer from relatively minor fungal infections, such as athlete’s foot and thrush, while more serious fungal infections are thought to cause around 1.5 million deaths worldwide each year. Human fungal disease burden could be greatly reduced by improving development of, and global access to, new antifungal treatments and rapid diagnostics. Strengthening public health capabilities and research on understanding and preventing fungal infection is also important.
-
Influenza
October 2011
Influenza or ‘flu’ is a viral infection that mainly affects the nose, throat and lungs. Good hygiene practices such as correct hand washing are essential to help prevent the spread of flu.
-
Legionnaires' disease
September 2012
Watch the Hot Topic Lecture: Legionnaires' disease - dead legs and shower heads, which featured at the Society for General Microbiology Autumn Conference held at University of Warwick, 3-5 September 2012.
-
Malaria
August 2012
Malaria is an infectious disease caused by a single-celled parasitic organism, Plasmodium, which infects the blood and liver.
-
Measles
June 2013
Measles is a viral disease spread through inhaling viral particles from infected coughs and sneezes.
-
Methicillin-resistant Staphylococcus aureus (MRSA)
November 2008
Staphylococcus aureus is a bacterium that is found on the skin and in the nose. It usually lives there completely harmlessly, this is called colonisation. Those resistant to the antibiotic meticillin are termed meticillin-resistant Staphylococcus aureus (MRSA)
-
Microbes and the food supply
May 2013
Microbiology is vital to preserve a sustainable, safe and secure food supply.
-
Microbiology and climate change
November 2015
Micro-organisms play crucial roles in climate change as users and producers of greenhouse gases. Climate change is increasing risks to public health and agriculture from microbial diseases. Managing and harnessing microbial processes could help us mitigate and adapt to climate change.
-
Norovirus
August 2009
Norovirus, also known as winter vomiting disease, is the most common cause of gastroenteritis (diarrhoea and vomitting) in the UK.
-
Polio
October 2013
Polio is a serious viral infection that can cause paralysis.
-
Schmallenberg
March 2012
Watch the Hot Topic Lecture Schmallenberg virus - fact from fiction, which featured at the Society for General Microbiology Spring Conference 2012 held at the Convention Centre Dublin, 26-29 March 2012.
-
Soil Health explainer
May 2020
The quality of soil and its suitability for growing crops has been important since humans developed agriculture. Back in 1888, Rhizobium spp. were found living in the roots of leguminous plants; first suggesting the importance of soil microbes. It is now known that soil microbiomes are diverse communities with complex interactions, made up of a vast array of bacteria, fungi, archaea, protists and viruses, which are crucial for carbon and nutrient cycling, plant health and even soil structure.
-
The Human Gut Microbiome
April 2024
Human microbiome research is an exciting and dynamic field that has the potential to benefit many areas of our society and the economy. Microbiome research has progressed rapidly since the development of new genomic technologies and investment in large-scale, collaborative projects such as The Human Microbiome Project, a ten-year research initiative launched in 2007 which set out to characterise the human microbiome and its role in health and disease. Evidence from this project, alongside more recent studies, suggests that the findings from microbiome research can be used to improve human health.
-
The Human Microbiota
February 2013
The human microbiota is the community of trillions of micro-organisms that live on and in the body. It can play a vital role in regulating our health and has been linked to diseases such as type II diabetes and Crohn’s disease. It is therefore under intensive scientific investigation.
-
Traveller's diarrhoea
February 2011
Traveller's diarrhoea (TD) is the most common illness that affects international travellers. Each year 20–60% of globetrotters, an estimated 10 million people, develop this diarrhoeal illness.
-
Tuberculosis
February 2012
Tuberculosis is a bacterial disease that caused illness in an estimated 8.8 million people globally in 2010 and led to 1.45 million deaths.
-
Tuberculosis Explainer
March 2019
Tuberculosis (TB) is a debilitating multi-organ disease caused by the bacterium Mycobacterium tuberculosis. The most important form of the disease is pulmonary TB, an infection of the lungs and respiratory tract. Other types of TB include TB meningitis and miliary TB, which are associated with high mortality in infants and young children.
-
Vaccines and immunisation
February 2008
Vaccines are substances that are introduced into the body to protect people and animals from infectious diseases by stimulating the immune system. Each vaccine targets the specific microbes that cause a disease. Vaccinated individuals are protected from the disease on subsequent exposure to infection because the immune system responds very quickly to the microbes.
-
Verocytotoxin-producing Escherichia coli (VTEC)
August 2008
Most strains of Escherichia coli are harmless. However, some produce powerful toxins that can cause serious illness. Verocytotoxin-producing Escherichia coli (VTEC) has caused a number of outbreaks of food poisoning in the UK.
-
Viruses and cancer
January 2012
Viruses and Cancer: Worldwide, viruses are associated with the development of around 15% of cancers. In 2010, viruses were found to be linked to around 9,750 (3%) cancer cases in the UK, with human papillomavirus (HPV) responsible for around half of these.